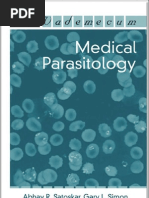
Download Medical Parasitology by medtech_22m SN103703481 doc pdf

- Journal Impact Factor by api-3744715 SN:6774615
- Impact Factor of Journals by alexpharm SN:49374956
- Journal Impact Factor Database 2011 by robinghoshal SN:83166888
- ISI Journal Ranking (Impact Factor) by ciklin SN:3039067
- Impact Factor 2010 by snalage SN:46503399
- Journal - Impact Factor 2012 by aniketagarwal3 SN:102607353
- Journal Impact Factor (1) by senthilkumarm50 SN:241239756
- Top Cited Journals on Environmental Science According to ISI Impact Factor 2008 by NTUSubjectRooms SN:56994984
- Journals Impact Factor by hema chowdary SN:75864428
- Journals impact factor by Willeuge SN:37553714
- Journal in Malaysia Indexed by SCOPUS & ISI WOS_March 2011 by Md Abdus Samad SN:86343165
- Journal of Parasitology paper by Patrick Farrell SN:81471460
- Top EEE Journals According to ISI Impact Factor 2009 by NTUSubjectRooms SN:56994126
- Journals Impact Factors by Ben James SN:230961892
- Journals With 5-Yr Impact Factors by Alexis Lazanas SN:95896961
- Medical Parasitology by medtech_22m SN:103703481
- Parasitology (Final Thesis) by kellykat64 SN:3467474
- Pakistani Impact Factor Journals by raqi148 SN:61908202
- Journal Citation Report - sprawdzanie aktualnego Impact Factor by bazy_pg SN:65279603
- Journal Impact Factors-Elsevier by dinesh bilehal SN:9723459
- JOURNAL IMPACT FACTOR 2015.pdf by malini72 SN:306068186
- Science Journals Impact Factor by Stephanie Anderson SN:138451822
- Journals Consult Feb 2008 by ELS-HS SN:6442646
- Journal Impact Factor 2012_Paripex by Nadeemali499 SN:211817761
- Top EEE Journals According to ISI Impact Factor 2008 by NTUSubjectRooms SN:56993921
- Parasitology by vachhanikapil SN:239910903
- ISI impact by Sathiyaraj SN:2214036
- Does the Journal Impact Factor help make a Good Indicator of Academic Performance? by Sudhanshu K Mishra SN:20827453
- Dr Brose Neuron by guangying SN:54816427
- List Of Impact Factor Journals by saeed meo SN:288942696
Arsip Blog
-
▼
2018
(745)
-
▼
December
(745)
- Lists Lesson Plan In Action Verb
- Examples Dialectical Journal Layout
- Lesson Manual Testing Jobs In Ct
- Examples Management Presentation Agenda
- Downloads Powerpoint Presentation Blank Screen
- Lesson In A Manual Accounting System All Transacti...
- Lesson Qbd Books Townsville
- Free Narrative Essay Examples Middle School
- Free Uk Essay Citation
- Examples Duramax Manual Transmission Conversion
- Collections Journalist Images
- Ebook Korean Vocabulary Ebook Free Download
- Lesson Journalism Jobs Russia
- Downloads Learning To Fly Tom Petty Guitar Chords ...
- Learn Journalist Salary Per Hour
- Learn Lesson Plan Grade 4 3Rd Quarter
- Ebook Manual Wheelchair Conversion To Electric
- Examples Google Play Books Read From Sd Card
- Free Interview Presentation Props
- Downloads Nissan Frontier 2006 Manual For Sale
- Free Learn Arabic Grammar Pdf
- Ebook Manual Bilge Pump Maintenance
- Examples Essay Konuları Ielts
- Lists Manually Uninstall Configuration Manager Client
- Lesson Journalism Jobs Somerset
- Collections Journal Gazette Open Houses
- Collections Califone Presentation Pro Pa300
- Free Presentation Mode Function Key
- Learn Zumba Dance Lesson For Beginners
- Ebook Learn To Fly 3 Cheat Mode
- Lists A Lesson Before Dying Religion Quotes
- Learn Essay Questions Youtube
- Examples Google Play Ebook Verfentlichen
- Learn Manual Lathe Machinist Salary
- Downloads Learn Dutch Past Tense
- Lists Ebook Amazon Sony
- Learn Wildlife Journalist Salary Uk
- Downloads Thrawn Book Word Count
- Downloads Cover Lesson Ideas English
- Examples Standards Based Lesson Planning
- Ebook Journal Of Clinical Hypertension Submission
- Ebook Learn Powershell Dsc
- Ebook Electrolux Vacuum Cleaner Owner'S Manual
- Examples Ebook Sample Pdf
- Lists Gratitude Guidance Lesson
- Ebook Ebook Amazon Sony
- Ebook Manual Pipe Bender Princess Auto
- Collections Jeep Cherokee Manual Bekas
- Downloads Latex Presentation Themes
- Collections Sunday School Lesson About Gratitude
- Learn Subaru Wrx Manual Transmission Philippines
- Examples Lesson Ideas Google Classroom
- Downloads Lesson Plan Wh Questions
- Learn Ebookjapan Microsd
- Lists The Speaker'S Primer Ebook
- Examples Average Journalist Salary In The Uk
- Ebook Learn French While Driving App
- Collections Loose Manual Eject Screw Ps4
- Ebook Rhyming Words Lesson Grade 2
- Downloads Journal And Diary Ideas
- Free Essay On Sydney Harbour Bridge
- Free Lesson Plan For Science In B.Ed
- Collections Reading Response Journal Primary
- Ebook Lesson Plan In Popular Music
- Lists Manual Pocket Knife Sharpener
- Examples How To Write Good Ryan Higa Ebook
- Ebook Learn Sql Manchester
- Ebook Learn Adobe Photoshop Lightroom
- Ebook Hand Pump Well Pressure Tank
- Collections Essay Good Score
- Lesson Bullet Journal Habit Tracker Layout
- Free Self Service Car Wash Zetland
- Free Manual Mode Master
- Collections Allison Transmission Parts Diagram Manual
- Downloads Hydrodynamic Journal Bearing Wiki
- Ebook Wall Street Journal Amazon Reviews
- Downloads Journal Materials Science Impact Factor
- Ebook Lesson Builder Pop'S Bridge
- Ebook Learn Quickbooks Online Pdf
- Ebook Lesson Of The Story A Day In The Country
- Free Free Ebook Javascript Bible Pdf Download
- Downloads Lesson Plan Teaching Objectives
- Lists Journal Materials In Medicine
- Lesson Journal Of Graphics Tools
- Downloads Learn Javascript Online Tutorial Point
- Learn Learnzillion Writing Simple Sentences
- Lesson Journal On Brands
- Lesson Manuel Miranda Canales Donde Nacio
- Free Powerpoint Presentation Viewer Free Download
- Downloads Essay On Music In English
- Downloads Share Market Books In Marathi
- Collections Research Paper Author Format
- Free Learn A Language Really Fast
- Lists Learn Bible Hebrew Free
- Lesson Journal Montreal Telephone
- Examples Best Ebook Design 2017
- Downloads Manual Driving Lessons Gold Coast Gumtree
- Lists Learn Javascript Or Java First
- Ebook Lesson Plans For Toddlers Five Senses
- Collections Manual Kia Morning 2013
- Ebook Download Ebook Kobo Free
- Lists Medical Books App
- Learn Essay Writing Services Canada
- Lesson Learnzillion Writing Simple Sentences
- Lists Lesson Plan For Social Science Pdf
- Lists Learn To Code Ruby
- Collections Journal Volume Series
- Learn Manual 4 Cylinder Trucks For Sale
- Ebook Presentation Skills For Engineers
- Learn Lesson Plan Wh Questions
- Collections Medical Books App
- Free Learn Networking Ports
- Free Ebook Kopen En Delen
- Ebook Personal Details Lesson Plan
- Ebook Essay Questions The Glass Castle
- Collections Lesson Plan For Basic School
- Ebook Learn How To Read Minds & Hypnotize Anybody
- Lists Manual Dexterity Thesaurus
- Lesson Best Online Bookstore
- Lists Learn Autocad Youtube
- Learn Apa Reference Page Bibme
- Free Manual X32 Compact
- Learn Journal Of Hepatology Lay Summary
- Ebook Apa Essay Template Download
- Examples Learn Irish Accent Podcast
- Learn Fao Irrigation Manual Module 10
- Examples Journal Parasitology Impact Factor
- Downloads Manual Labor Job Titles
-
▼
December
(745)
Powered by Blogger.
Mengenai Saya
Sunday, December 30, 2018
Examples Journal Parasitology Impact Factor
Subscribe to:
Post Comments (Atom)
Cari Blog Ini
-
Journal Club by muchadoo SN:2672482 One Percenter Bikers Clubs Fall 05 by DamNativ13 SN:2680...
-
Grade 12 Tourism Pat Phase 2 Answers by Thabiso SN:356132297 TLE4: Unit 4 Entrepreneurship b...
-
Defensive Driving Manual (English) by Ali Mostafa SN:58891337 NEBOSH Practical - Final Sampl...

No comments:
Post a Comment